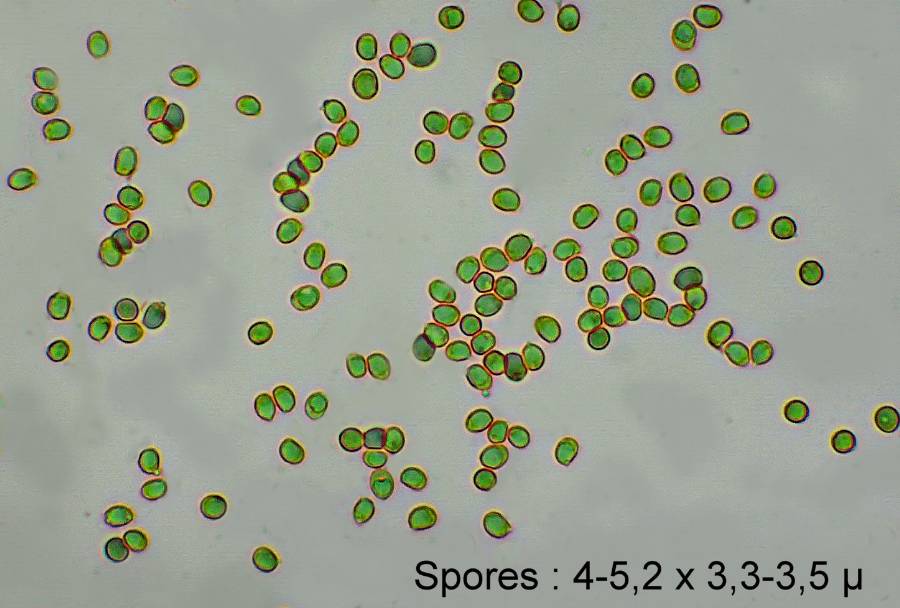
Calocybe gambosa (à confirmer) 2013 10 24 Lozère (Barre-des-Cévennes) 2.jpg

|
|
|
|
Nous sommes le 31 Octobre 2025, 23:21
|
Voir les messages sans réponses | Voir les sujets actifs
 
|
Page 1 sur 1
|
[ 5 messages ] |
|
Saint-Georges en octobre ?
| Auteur |
Message |
|
olivier48
Inscription: 03 Novembre 2012, 21:23
Messages: 99

|
 Saint-Georges en octobre ? Bonjour !
Je ne connais pas le Mousseron ou Tricholome de la Saint-Georges (Calocybe gambosa) qui doit pourtant être familier à nombre d’entre vous.
J’ai trouvé, hier, en terrain calcaire, un champignon qui lui ressemble beaucoup, dans un bois de pins sylvestres et chênes blancs où poussent aussi des aubépines, de la bruyère et de l’herbe, donc un bois très clair.
Je me demande s’il ne s’agit pas de ce fameux Calocybe gambosa, bien que le biotope, et surtout la saison, ne « collent » pas (toutes les récoltes de la Liste MycoDB se situent entre fin mars et fin mai). Il poussait en ligne, très serré. L’odeur ne m’a pas paru très « farineuse » ; je dirais plutôt « de champignon » (ce critère est si subjectif entre nous !).
La peau du chapeau est très lisse (douce au toucher) ; le haut du pied est un peu granuleux.
Je joins deux photos.
De quelle autre espèce pourrait-il s’agir ?
Bien cordialement.
Marc.
Fichiers joints:
 Calocybe gambosa (à confirmer) 2013 10 24 Lozère (Barre-des-Cévennes) 2.jpg [ 55.99 Kio | Vu 17871 fois ]
Calocybe gambosa (à confirmer) 2013 10 24 Lozère (Barre-des-Cévennes) 2.jpg [ 55.99 Kio | Vu 17871 fois ]
Calocybe gambosa 2013 10 24 ( à confirmer) Lozère (Barre-des-Cévennes).jpg [ 127.06 Kio | Vu 17871 fois ]
Calocybe gambosa 2013 10 24 ( à confirmer) Lozère (Barre-des-Cévennes).jpg [ 127.06 Kio | Vu 17871 fois ]
|
| 25 Octobre 2013, 12:08 |

|
 |
|
Andgelo
Inscription: 10 Mai 2013, 19:00
Messages: 118
Localisation: Doubs

|
 Re: Saint-Georges en octobre ? Bonjour,
Cela na vraiment pas l'allure d'un gambosa.
Ta récolte m'évoque plutôt Tricholoma acerbum, bien que les spores me semblent bien petites...
_________________
Andgelo
|
| 25 Octobre 2013, 12:14 |
 
|
 |
|
Obsoleta
Inscription: 19 Novembre 2012, 12:20
Messages: 382

|
 Re: Saint-Georges en octobre ? Bonjour dans la grisaille.
Même avis qu'Andgelo. A noter que cette espèce classée dans le genre Tricholoma évoque d'avantage l'aspect d'un Leucopaxillus que d'un Tricholoma. Les spores de T. acerbum ne sont pas amyloïdes contrairement à celles des Leucopaxilles.
Bonne fin de journée.
|
| 25 Octobre 2013, 13:50 |

|
 |
|
olivier48
Inscription: 03 Novembre 2012, 21:23
Messages: 99

|
 Re: Saint-Georges en octobre ? Eh oui, Andgelo et Michel, vous avez raison ! Il s’agit sûrement de Tricholoma acerbum.
Parti sur une fausse piste, j’ai bien fait de demander.
Cette fois, les critères sont plus convaincants. J’ajoute que les lames se tachent de rouille et les bords du chapeau présentent des cannelures.
Les spores sont petites, en effet, mais, dans la famille des tricholomes, celles d’acerbum sont aussi parmi les plus petites. Selon les auteurs, les tailles varient : 5-6 x 4-5 (Eyssartier et Roux) ; 5,5 x 4 (Bon) ; 4-5 x 3,7-4,5 (Marchand) et 4-6 x 3-4 (Roger Phillips). Nous ne sommes pas si loin...
Quant au critère « amyloïdes ou non amyloïdes » (réagissent ou non à l’iode), je dois étudier la question de plus près car je débute en réactifs chimiques.
Merci beaucoup.
Bonne fin de journée (très grise et pluvieuse ici en Cévennes).
Marc.
|
| 25 Octobre 2013, 16:44 |

|
 |
|
GAUDICHAU
Inscription: 19 Septembre 2009, 20:34
Messages: 36

|
 Re: Saint-Georges en octobre ? Bonjour a tous
Tricholoma roseoacerbum probablement
En quantité à la session SMF de Nouan le fuzelier
Bon décalage horaire.........
Claude
|
| 27 Octobre 2013, 04:55 |

|
|
 
|
Page 1 sur 1
|
[ 5 messages ] |
|
Qui est en ligne |
Utilisateurs parcourant ce forum: Bing [Bot], Google [Bot], Majestic-12 [Bot] et 66 invités |
|
Vous ne pouvez pas poster de nouveaux sujets
Vous ne pouvez pas répondre aux sujets
Vous ne pouvez pas éditer vos messages
Vous ne pouvez pas supprimer vos messages
Vous ne pouvez pas joindre des fichiers
|
|

